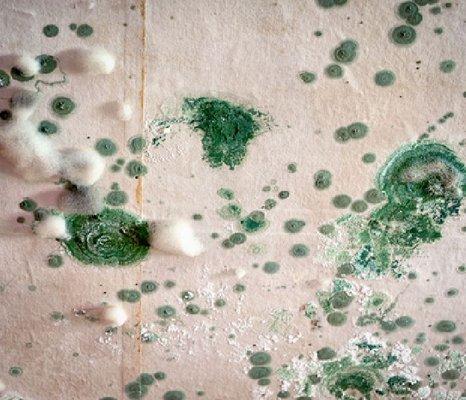

Dallas - Highland Park Village
Closed
Advertisement
Photos
45 Highland Park Vlg
Dallas, TX 75205
Visit your local boutique at 45 Highland Park Village in Dallas. Founded in 1755, Vacheron Constantin is the world’s oldest watch Manufacture in continuous production for over 267 years, faithfully perpetuating a proud heritage of watchmaking excellence and stylistic sophistication through generations of master craftsmen. At the pinnacle of Haute Horlogerie and understated elegance, the Maison creates timepieces with unique technical and aesthetic signatures, and an extremely high level of finishing touches. Vacheron Constantin brings to life unparalleled heritage and a spirit of innovation through its collections: Patrimony, Traditionnelle, Métiers d’Art, Overseas, Fiftysix, Historiques and Égérie. It also offers its discerning clientele of connoisseurs the rare opportunity to acquire vintage pieces within the Les Collectionneurs assortment, as well as unique and bespoke timepieces by means of its Les Cabinotiers department.
Also at this address
Find related places
Owner verified
See a problem?
In these collections
You might also like
Advertisement